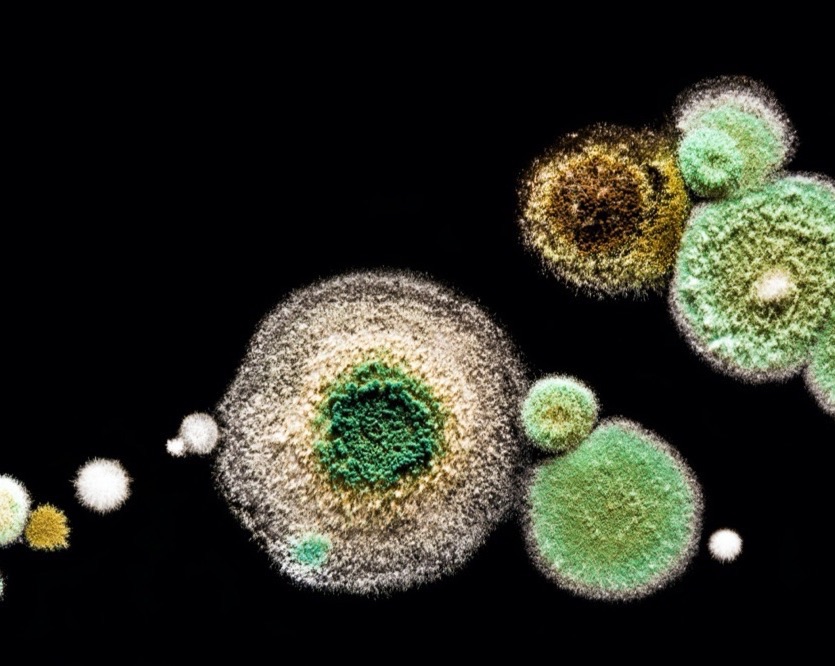

Was wir tun
Strategie und change management
... beides exzellent zu machen nehmen wir sehr ernst, denn es sichert die Nachhaltigkeit Ihres Unternehmens.
Mehr erfahrenModerne Strategieentwicklung verstehen wir als eine nicht delegierbare, gemeinschaftliche Führungsleistung des Unternehmens.
Und schon mit ihrer Entwicklung beginnt die Umsetzung einer neuen Strategie!
Deshalb binden wir in einem konsequenten, schlanken Prozess die wesentlichen Akteure - möglichst aus allen Bereichen der Organisation - von Anfang an mit ein: die Kernfragen der Strategieentwicklung werden gemeinsam beantwortet und verantwortet. Sie erreichen so ein Höchstmaß an sachlicher Klugheit zusammen mit einem Maximum an Akzeptanz und Umsetzungswillen!
In einem integrierten Veränderungsprozess führen wir strategieorientierte, geplante organisatorische Veränderungen in ihrem Unternehmen. Wir arbeiten dabei ausdrücklich und gezielt an Strukturen und Prozessen sowie Beziehungen, Werten/Kulturen, Einstellungen und Verhalten.

ORGANISATION...
... ist immer ein mächtiges Mittel zur Umsetzung von Unternehmes-Strategie und Unternehmens-Werten
Mehr erfahrenORGANISATION...
- ist immer ein mächtiges Mittel zur Umsetzung von Unternehmes-Strategie und Unternehmens-Werten.
- ist nur so gut, wie es im Rahmen der Organsiation gelingt, die Herausforderungen an die Firma zu bewältigen.
- muss sich so weiter entwickeln, wie sich auch die Anforderungen an das Unternehmen entwickeln - nämlich ORGANisch.
- ist immer eine Hypothese, ein Konzept, das wir Menschen entwickelt haben und wir eben deshalb auch verändern können:
"Mit welcher Aufbau- und Prozessorganisation können wir in Zukunft die Vision und die strategischen Ziele erreichen?"
- wird deshalb mit unseren Auftraggebern zum richtigen Zeitpunkt hinterfragt und weiter entwickelt: Nämlich dann, wenn die Vision und die Werte formuliert und die strategischen Ziele definiert sind!
Menschen und Teams
... stehen in unserem Fokus - sie machen jedes erfolgreiche Unternehmen erst möglich
Mehr ErfahrenDie Professionelle ROLLE
Die Professionelle Rolle von Mitarbeiter*innen wird in Zukunft zu dem zentralen Entwicklungsfeld in Unternehmen: hier entscheidet sich, ob das Rennen um Innovationskraft, Agilität, höchste Qualität und Attraktivität als Arbeitgeber verloren oder gewonnen wird!
Wir helfen Ihnen bei der Entwicklung und Einführung moderner Personalinstrumente: Das Ziel ist es, eine einzigartige Passung von „Talent und Entwicklungsinteresse der Mitarbeitenden“, sowie „Bedarf des Unternehmens“ zu erreichen.
TEAM-FORMATION
Zu Beginn jedes Veränderungsprozesses liegt in unserem Vorgehen der Fokus nicht auf „klugen Inhalten“ - zuallererst geht es immer darum, eine exzellente Arbeitsgrundlage im (Strategie) Team zu schaffen:
Das ist kein netter „Teambuilding-Workshop“, sondern hier geht es ans Eingemachte: Denn nur wenn es eine starke Vereinbarung zum gemeinsamen Ziel und eine verbindliche Zusage aller zur gemeinsamen Verantwortung gibt, dann gibt es auch ein gemeinsames und koordiniertes Handeln bei Strategieentwicklung und -umsetzung!
Und nur wenn die Einzelnen dabei konstruktiv zusammen arbeiten, sich Ihrer Wirkung und Rolle im Team eindeutig bewusst sind und sich gute und unterstützende Prozesse der Zusammenarbeit etablieren, arbeitet ein Team exzellent.

New Work
... wir verstehen darunter TRUE WORK
Mehr ErfahrenNew Work
- Bedeutet farbenfrohe, spielerische Arbeitsumgebungen und Home Office?
- Bedeutet: Keine Hierarchie = keine Regeln?
- Bedeutet, dass Agilität und Flexibilität als Methode eingeführt werden können?
NEIN. New Work ist nicht nur eine Veränderung an der Oberfläche und nicht mit Selbstüberlassung gleichzusetzen!
Neue Arbeit bedeutet in unserem Verständnis
- Arbeitsumgebungen und -prozesse, die Menschen optimal bei ihren Aufgaben in der ZUKUNFT unterstützen
- Im Wesentlichen eine Veränderung der Machtverteilung: Entscheidungen werden viel häufiger dort getroffen, wo sie anfallen.
- Einen Zielzustand, in dem komplexe Aufgaben unter veränderten Anforderungen möglichst schnell und selbstständig bearbeitet werden.
New Work ist eine Haltung, die je nach Unternehmen unterschiedlich umgesetzt wird. ToChange kann mit ihnen zusammen daran arbeiten, diese gemeinsame Haltung und den entsprechenden Prozess zu entwickeln, um die wesentlichen Elemente Ihres Managementsystems entsprechend zu transformieren.


Alle Rechte Vorbehalten
Kontaktiere Uns
-
+49-(0)941 600 93 003
-
Diese E-Mail-Adresse ist vor Spambots geschützt! Zur Anzeige muss JavaScript eingeschaltet sein. -
Thomas_Huber
ToChange Gmbh
-
Thomas Huber
-
Traubengasse 6
-
D-93059 Regensburg

